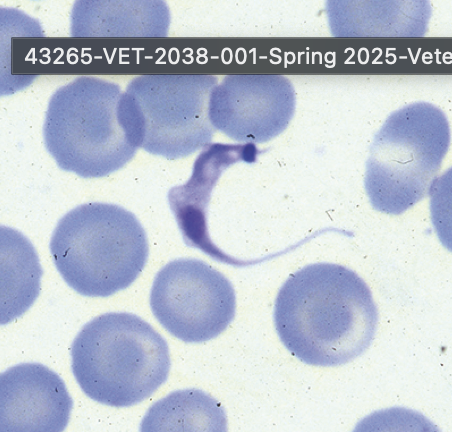
<p><em>Trypanosoma cruzi</em> - Chagas disease (trypomastigote)</p>

Parasite identification list combined
1/29
There's no tags or description
Looks like no tags are added yet.
Name | Mastery | Learn | Test | Matching | Spaced |
|---|
No study sessions yet.
30 Terms

This was found on a sheep with very poor-quality wool. What is it?
Melophagus ovinus - sheep ked (Adult)

Identify this parasite
Cuterebra spp. rodent or rabbit bot fly (larva)

Identify this parasite
Trichodectes canis (dog chewing louse)

Identify this parasite
Felicola subrostratus (cat chewing louse)

This was found on an anemic pig. What is it?
Haematopinus suis - pig sucking louse (Nymph or adult)

This was found in the fur of a kitten. What is it?
Ctenocephalides felis - cat flea (Adult)

Identify this tick (scientific and common names) and name two or more diseases that it transmits.
Ixodes scapularis - deer tick
It transmits Lyme and Anaplasmosis

Identify this tick (scientific and common names) and name two or more diseases that it transmits.
Rhipicephalus sanguineus - brown dog tick (adult)
It transmits Ehrlichia and Rocky mountain fever.

Identify this tick (scientific and common names) and name two or more diseases that it transmits.
Dermacentor variabilis - American dog tick, spotted fever tick (adult)
It transmits Rocky mountain fever and Tularemia.

Identify this tick (scientific and common names) and name two or more diseases that it transmits.
Amblyomma americanum - lone star tick (adult)
It transmits Ehrlichia and Rickettsiosis.

This was found on a dog with intense pruritus. What is it? Is it contagious to humans?
Sarcoptes scabiei - sarcoptic mange mite (adult)
yes it’s contagious.

This was found on a dog with a small, well circumscribed hairless area on his front leg. What is it? Is it contagious to humans?
Demodex spp. - follicle mite (adult)
no it isn’t contagious.

This was found in the ear of a kitten. What is it?
Otodectes cynotis - ear mite (Adult)

This was found in the stool sample of a coughing cat. What is it?
Paragonimus kellicotti - lung fluke (egg)


This was found in the stool sample of a dog with no associated clinical signs. What is it?
Dipylidium caninum - double-pored tapeworm (egg)

This was found in a stool sample of a young scouring pig. What is it?
Ascaris suum - large roundworms of pigs (egg)

This was found in a stool sample of a coughing puppy with diarrhea. What is it?
Toxocara canis - canine roundworm (egg)

What parasite causes a “Moroccon Leather” appearance on the abomasal mucosa?
Ostertagia ostertagi (brown stomach worm)

This was found in a stool sample of an anemic sheep. What is it most likely to be?
Haemonchus contortus (barberpole worm)


This was found in a stool sample of a colicky horse. Name one kind of worm it could be.
Strongylus vulgaris - bloodworm of horses (egg)


This was found in the urine of a pig. What is it?
Stephanurus dentatus - kidney worm of pigs (egg)

This was found in a stool sample of a dog with bloody stool. What is it?
Ancylostoma caninum - canine hookworm (egg)


This was found in a stool sample of a dog with black tarry stool. What is it?
Trichuris spp. - whipworm (egg)


This parasite encysts in muscle tissue and is nonpathogenic to its porky host. What is it?
Eucoleus (Capillaria) aerophilus - pork worm (larva)

This was found in the blood of a dog. What is it?
Dirofilaria immitis - heartworm (microfilaria)


This was found in a stool sample of a coughing cat. What is it?
Aelurostrongylus abstrusus - feline lungworm (larva)

This was found via the Baermann Technique in a stool sample of a coughing cow. What is it?
Dictyocaulus viviparus - cattle lungworm (larvae)

This was found on a blood smear from a dog in a kennel in Louisiana where many young dogs are dying. Others are anemic and febrile. What is it?
Trypanosoma cruzi - Chagas disease (trypomastigote)

This was found on a direct fecal saline smear of a puppy with diarrhea. What is it?
Giardia duodenalis - trophozoite

This was found on a zinc sulfate fecal flotation (iodine added) of a puppy with diarrhea. What is it most likely to be?
Giardia duodenalis - cysts